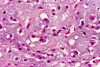
Com306-1-HM1.gif (138921 bytes)
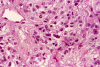
Com306-1-hm3.gif (141362 bytes)
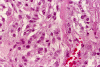
Com306-1-HM2.gif (137867 bytes)

| A 45 year-old Woman with an Enhancing Brain
Mass. June, 2003, Case 306-1. Home Page |
Clinical information: The patient was a 45 year old woman with a headache. MRI revealed a strongly enhancing dural based tumor of the falx cerebri. Edema was noted in the surrounding brain tissue but no mass effect was noted. Surgery yielded the following specimen.
 |
 |
 |
 |
|
 |
| A. | B. | C. | D. | E. | F. |
 |
|
|
|||
| G. | H. | I. |
What is your diagnosis? Discussion